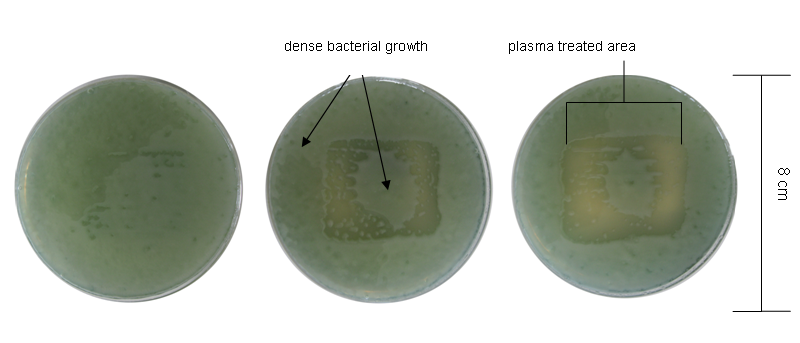
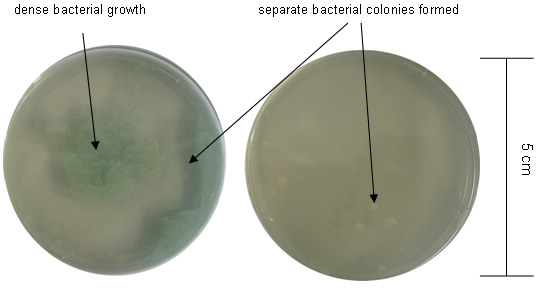

Screening test for quality control of surface barrier discharged plasma sources with the microorganism-agar test (MAT)
Rutger Matthes 1Nils-Olaf Hübner 1
Claudia Bender 1
Ina Koban 2
Klaus-Dieter Weltmann 3
Axel Kramer 1
1 Institute for Hygiene and Environmental Medicine, University of Greifswald, Germany
2 Unit of Periodontology, Dental School, University of Greifswald, Greifswald, Germany
3 Leibniz Institute for Plasma Science and Technology (INP), Greifswald, Germany
Abstract
In the recent past, the antimicrobial applicability of tissue tolerable plasma (TTP) has been examined, and is increasing in importance. Many different plasma sources can be used medically. In order to obtain reliable test results by using plasma sources, it is essential not only to assess physical parameters but also to screen a use-oriented application of plasma sources. It is necessary to both determine the biological efficacy and establish uniform coverage of the treated surfaces. This article shows a simple screening method for this. We used newly inoculated agar plates with bacterial test organisms and treated the agar plates with two surface barrier discharged (SDB) plasmas. The carrier gas was argon and air.
Keywords
Tissue Tolerable Plasma (TTP), barrier discharge sources, SBD, quality screening, microorganism-agar test (MAT), Pseudomonas aeruginosa, Staphylococcus epidermidis
Introduction
Physical plasmas have been used as an alternative method for sterilization in the medical field for more than a decade [1], [2]. Recently, the applications of tissue tolerable plasma (TTP) on body surfaces have become more important, especially for the treatment of chronic wounds [3], [4], [5]. For medical use, different types of TTP can be selected; a review of plasma sources is described by Kong et al. [6] and Weltmann et al. [7]. Not only plasma jets but also dielectric barrier (DB) plasmas are suitable for wound treatment. SBDs are especially suitable for the treatment of larger surfaces, because the plasma is produced over the entire area. Plasma jets are suitable for treating punctiform areas and can be applied flexibly through tubes.
The effectiveness of plasma sources can vary greatly. The number of application forms alone or options to modulate the output (e.g., parameters of frequency, voltage) of a plasma source provide a versatile range of plasma effects. There are also less obvious influences which modulate the effects. Even plasma sources with identical technical parameters can produce variable physicochemical effects on biological systems within the same series of trials. The cause may be variations of the temperature, altered production of radical species, or inconstant intensity of UV radiation. In order to obtain reliable test information about the efficacy of plasma sources, it would be helpful to have a simple screening test that documents the constancy and even distribution plasma on areas exposed to it. Microorganisms cultured on nutrient agar plates are the logical choice as the test object.
To test the anti-biofilm activity of plasma, microorganisms must attach to surfaces and, under suitable conditions, develop into a biofilm. After treating the biofilm with plasma, the microorganisms are removed from the surfaces and put into suspension [8]; however, this does not directly demonstrate the constancy and uniformity of plasma effects. The same is true of applying plasma to inhomogeneous surfaces such as wound tissue, where irregular effects may be attributed to the inhomogeneous structure of the surface.
This article examines the suitability of the microorganism agar test (MAT) as a screening method for surface barrier discharged (SBD) plasma sources to determine the homogeneity of their effects. The tests were carried out with two different SBD plasma sources.
Method
Germ suspension
The bacterial strains used for the tests, Pseudomonas aeruginosa SG81 and Staphylococcus epidermidis RP62A, produce biofilms. Pseudomonas aeruginosa SG81 (P. aeruginosa) was isolated out of a technical water system and has been well characterized [9]. Staphylococcus epidermidis RP62A (S. epidermidis) is used by many researchers as a biofilm-producing reference strain [10], [11], [12], [13].
A glass bead with attached bacteria of the test strain was transferred onto a blood agar plate (Columbia Agar + 5% sheep blood, bioMérieux, Nürtingen, Germany) under aseptic conditions to prepare the first subculture. This was incubated for 24 h at 37°C. From this, further subcultures were started on new blood agar plates and incubated for 24 h at 37°C. Afterwards, the grown colonies were rinsed off into a test tube and washed 3 times with phosphate buffered saline solution (PBS) by centrifugation at 2500 rpm for 15 min each time. Between the washing steps, the supernatant liquid was decanted. The remaining pellets were each resuspended in 10 ml of PBS. A serial dilution was prepared to yield an end concentration of the bacterial suspension of 105 colony forming units (CFU)/ml.
Test preparation
Petri dishes with diameters of 55 mm (TPP, Trasadingen, Switzerland) and 96 mm (Sarstedt, Nümbrecht, Germany) were prepared with CASO agar (Roth, Karlsruhe, Germany). Next, the prepared bacterial suspension was spread with a sterile cotton swab over the agar. A drying time of 30 min was maintained to provide uniformly dry agar plates for the subsequent plasma treatment. The plasma-treated bacteria were incubated for 24 h (P. aeruginosa) and 48 h (S. epidermidis) at 37°C.
Plasma treatment
Two different SBD electrodes were screened. Plasma source A had the following parameters: UPP = 4 kV, 30 kHz, pulsed 250 ms on-time, 750 ms off-time, argon gas flow 5 standard liters/min (slm). The parameters of plasma source B were: UPP = 3 kV, 40 kHz, pulsed 250 ms on-time, 750 ms off-time, argon gas flow 0.5 slm (both sources were developed by the Leibniz Institute for Plasma Science and Technology e.V. Greifswald, Germany).
The plates were treated for 30 s, 60 s and 120 s by plasma source A, and for 60 s to 6 min by plasma source B. The distance between the electrodes and the agar was 2 mm. Before starting the argon plasma treatment, the treatment area was shielded to exclude influences from the environment and the space between the electrode and the agar surface was “rinsed” with argon for 1 min.
Results
The area of the agar plates treated by argon plasma source A (gas flow 5 slm) was approximately 12 cm2 (Figure 1 [Fig. 1] and Figure 2 [Fig. 2]). Bacterial growth decreased with increased duration of plasma exposure. However, in the center of the treatment area, P. aeruginosa (Figure 1 [Fig. 1]) and S. epidermidis (Figure 2 [Fig. 2]) retained their ability to form colonies.
Figure 1: Plasma source A, argon, treatment duration from left to right 30 s, 60 s, 120 s, Pseudomonas aeruginosa SG81
Figure 2: Plasma source A, argon, treatment duration from left to right 30 s, 60 s, 120 s, Staphylococcus epidermidis RP62A 
Agar plates air treated (without gas flow) with plasma source A are shown in Figure 3 [Fig. 3] and Figure 4 [Fig. 4]. After 30 s of plasma treatment, distinct inactivation of P. aeruginosa (Figure 3 [Fig. 3]) and S. epidermidis (Figure 4 [Fig. 4]) was observed.
Figure 3: Plasma source A, air, treatment duration from left to right 30 s, 60 s, 120 s, Pseudomonas aeruginosa SG81 
Figure 4: Plasma source A, air plasma, treatment duration from left to right 30 s, 60 s, 120 s, Staphylococcus epidermidis RP62A 
Viable bacteria were still visible in the upper right plasma treated area after 30 s of treatment. The edges on the right side of the plasma treated area appeared much more irregular.
Figure 5 [Fig. 5] shows agar plates bearing cultures of P. aeruginosa and S. epidermidis treated with argon plasma from source B (gas flow 0.5 slm). The plasma-treated area was a circle of approximately 10 cm2. Both agar plates in Figure 5 [Fig. 5] were fully covered with biofilm growth.
Figure 5: Plasma source B, argon plasma, treatment duration 6 min, Pseudomonas aeruginosa SG81 (left, dense growth) and Staphylococcus epidermidis RP62A (right, dense growth) 
Agar plates with S. epidermidis and P. aeruginosa after an identical air plasma treatment (without gas flow) are shown in Figure 6 [Fig. 6] and Figure 7 [Fig. 7]. On the left, obvious bacterial growth on agar was evident, while only some colonies were visible on the agar plate on the right after identical durations of plasma treatment.
Figure 6: Plasma source B, air plasma, treatment duration 1 min, Pseudomonas aeruginosa SG81 
Figure 7: Plasma source B, air plasma, treatment duration 2 min, Pseudomonas aeruginosa SG81
Discussion
The treatment of bacteria spread on culture medium is a simple test, often used to test the antimicrobial efficacy of plasma sources, for example in Pompl et al. [14], Laroussi et al. [15], Shimizu et al. [16] and Morfill et al. [17]. The MAT is also a practical means of obtaining information about the quality of the plasma treatment in terms of stability and homogeneity.
An inactivation zone is visible inside the treated area (Figure 1 [Fig. 1], Figure 2 [Fig. 2], plasma source A), and becomes more distinct with longer treatment durations. However, a vital zone persists in the center of the treated area, independent of the length of plasma exposure. In contrast, this phenomenon is not visible in Figure 3 [Fig. 3] and Figure 4 [Fig. 4] despite the fact that the same plasma source (A) was used. Nevertheless, all figures show that the right edge of the treated area exhibits fringes. The difference between the two plasma applications was the carrier gas used: in Figure 1 [Fig. 1] and Figure 2 [Fig. 2], the agar plates were treated with argon plasma and in Figure 3 [Fig. 3] and Figure 4 [Fig. 4] with air plasma. An influence of the ambient air on the argon plasma can be excluded, because the treatment was shielded. An irregular spread of the reactive “after glow” under the electrode area is postulated for the results shown in Figure 1 [Fig. 1] and Figure 2 [Fig. 2]. Additionally, comparing the two bacterial strains, it is apparent that S. epidermidis is less sensitive to argon plasma than is P. aeruginosa, because more colonies of the former were formed after the same treatment duration.
Figure 5 [Fig. 5] shows P. aeruginosa and S. epidermidis after 6 min of plasma treatment by plasma source B. No inactivation was observable; the culture medium is fully covered with biofilm growth. The results of plasma source A, which showed an antimicrobial effect after just 30 s of plasma exposure, make it clear that the biological effect of a particular plasma type (here SBD) depends on the design and the input power per treated area of the source. An input power threshold value may exist for an antimicrobial effect of argon plasma. It is interesting that the different sensitivity of the two bacterial strains to argon plasma was not observable after treatment with air plasma (Figure 3 [Fig. 3] and Figure 4 [Fig. 4]).
The effect on P. aeruginosa is quite evident in Figure 6 [Fig. 6] and Figure 7 [Fig. 7]. The inactivation of that bacterial species is different in Figure 6 [Fig. 6] and Figure 7 [Fig. 7], although they were subjected to the same treatment. Several identical plasma source B devices were available, so that two parallel plasma treatments of different dishes were possible.
The results with S. epidermidis are not presented, because after 1 min of treatment with air plasma, no growth was visible. It is conceivable that S. epidermidis is more sensitive to air plasma than is P. aeruginosa.
The results of our study showed that variations in antimicrobial efficacy could be caused by small differences in the design of a plasma application and even between two identical devices. For this reason, our laboratory intends to routinely perform the screening method MAT before testing special medical plasma applications.
The MAT is useful for all plasma applications which are not restricted to demonstrating the antimicrobial effect of a particular source/device. Examples are treatments of liquids, biofilms, cell cultures, or surfaces.
The light emission of the produced plasma is often only visually assessed. Not only ambient factors (i.e., room temperature, air humidity, oxygen content) can influence the uniformity of plasma efficacy, but also certain unidentified technical factors inherent in the equipment itself (i.e., the spread of “after glow”) can play a role.
In order to employ the MAT reliably, the microorganisms must be spread evenly over the agar plate; this prevents gross variations in microorganism density. The agar surface must be flat and horizontal to ensure a constant distance to the SBD electrode.
Conclusion
Pre-tests of the plasma source are advised to avoid misinterpretations; this is especially important for plasma sources which are still in the developmental stage. The MAT is a helpful tool to observe the quality and efficacy of SBD plasma sources. That screening method require at least 24 h to asses the quality of stability and homogeneity for using new plasma sources.
Acknowledgements
This work was realized as part of the multidisciplinary cooperative research project ‘Campus PlasmaMed’ within the program ‘PlasmaCure’. This work was supported by a grant from the German Ministry of Education and Research (BMBF, grant No. 13N9779).
References
[1] Höller C, Martiny H, Christiansen B, Rüden H, Gundermann KO. The efficacy of low temperature plasma (LTP) sterilization, a new sterilization technique. Zentralbl Hyg Umweltmed. 1993;194(4):380-91.[2] Chau TT, Kao KC, Blank G, Madrid F. Microwave plasmas for low-temperature dry sterilization. Biomaterials. 1996;17(13):1273-7. DOI: 10.1016/S0142-9612(96)80003-2
[3] Kramer A, Lindequist U, Weltmann KD, Wilke C, von Woedtke T. Plasma Medicine – its perspective for wound therapy. GMS Krankenhaushyg Interdiszip. 2008;3(1):Doc16. Available from: http://www.egms.de/en/journals/dgkh/2008-3/dgkh000114.shtml
[4] Weltmann KD, von Woedtke T, Brandenburg R, Ehlbeck J. Biomedical applications of atmospheric pressure plasma. II Central European Symposium on Plasma Chemistry 2008. Chem Listy. 2008;102:s1450-s1451. Available from: http://www.chemicke-listy.cz/docs/full/2008_16_s1450-s1451.pdf
[5] Lloyd G, Friedman G, Jafri S, Schultz G, Fridman A, Harding K. Gas Plasma: Medical Uses and Developments in Wound Care. Plasma Process Polym. 2010;7:194-211. DOI: 10.1002/ppap.200900097
[6] Kong MG, Kroesen G, Morfill G, Nosenko T, Shimizu T, van Dijk J, Zimmermann JL. Plasma medicine: an introductory review. New J Phys. 2009;11:115012. DOI: 10.1088/1367-2630/11/11/115012
[7] Weltmann KD, Kindel E, von Woedtke T, Hähnel M, Stieber M, Brandenburg R. Atmospheric-pressure plasma sources: Prospective tools for plasma medicine. Pure Appl Chem. 2010;82(6):1223-37. DOI: 10.1351/PAC-CON-09-10-35
[8] Koban I, et al. Killing and removal of dental biofilms from titanium implant surfaces. In: BMT 2010. (BMT 2010 Reguläre Beiträge). Rostock-Warnemünde, Germany; 2010.
[9] Grobe S, Wingender J, Trüper HG. Characterization of mucoid Pseudomonas aeruginosa strains isolated from technical water systems. J Appl Bacteriol. 1995;79(1):94-102.
[10] Christensen GD, Barker LP, Mawhinney TP, Baddour LM, Simpson WA. Identification of an antigenic marker of slime production for Staphylococcus epidermidis. Infect Immun. 1990;58(9):2906-11.
[11] Anglen J, Apostoles PS, Christensen G, Gainor B, Lane J. Removal of surface bacteria by irrigation. J Orthop Res. 1996;14(2):251-4. DOI: 10.1002/jor.1100140213
[12] Sadovskaya I, Vinogradov E, Flahaut S, Kogan G, Jabbouri S. Extracellular carbohydrate-containing polymers of a model biofilm-producing strain, Staphylococcus epidermidis RP62A. Infect Immun. 2005;73(5):3007-17. DOI: 10.1128/IAI.73.5.3007-3017.2005
[13] König DP, Perdreau-Remington F, Rütt J, Stossberger P, Hilgers RD, Plum G. Slime production of Staphylococcus epidermidis: increased bacterial adherence and accumulation onto pure titanium. Acta Orthop Scand. 1998;69(5):523-6. DOI: 10.3109/17453679808997791
[14] Pompl R, et al. The effect of low-temperature plasma on bacteria as observed by repeated AFM imaging. New J Phys. 2009;11:115023. DOI: 10.1088/1367-2630/11/11/115023
[15] Laroussi M, Tendero C, Lu X, Alla S, Hynes WL. Inactivation of Bacteria by the Plasma Pencil. Plasma Process Polym.2006;3(6-7):470-3. DOI: 10.1002/ppap.200600005
[16] Shimizu T, Steffes B, Pompl R, Jamitzky F, Bunk W, Ramrath K, et al. Characterization of Microwave Plasma Torch for Decontamination. Plasma Process Polym. 2008;5(6):577-82. DOI: 10.1002/ppap.200800021
[17] Morfill GE, Shimizu T, Steffes B, Schmidt HU. Nosocomial infections-a new approach towards preventive medicine using plasmas. New J Phys. 2009;11:115019. DOI: 10.1088/1367-2630/11/11/115019



